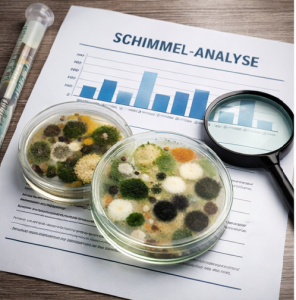

Neu bei uns: Professionelle Schimmel- und Raumluft-Checks
Ab sofort erweitern wir unser Leistungsangebot um umfassende Schimmel-Checks, Material-Checks und Raumluft-Analysen. Mit modernen Mess- und Analyseverfahren sorgen wir für Klarheit, Sicherheit und ein gesundes Raumklima – zuverlässig, diskret und fachlich fundiert.
Unsere neuen Leistungen im Überblick:
-
Schimmel-Checks
Fachgerechte Untersuchung von sichtbarem und verstecktem Schimmelbefall inklusive Ursachenanalyse. -
Material-Checks
Prüfung von Baustoffen und Oberflächen auf Feuchtigkeit, Schadstoffe oder mikrobiellen Befall. -
Raumluft-Checks
Analyse der Raumluft auf Schimmelsporen, Schadstoffe und andere gesundheitsrelevante Belastungen. -
Profi-Checks
Erweiterte Untersuchungen für anspruchsvolle Objekte, Vermieter, Unternehmen oder Versicherungen. -
Raumluft-Kombi-Checks
Kombinierte Messungen von Raumluft und Materialien für eine ganzheitliche Bewertung der Wohn- oder Arbeitsumgebung.
Unsere Checks eignen sich für Privathaushalte, Mietobjekte, Gewerbe- und Industrieflächen. Sie erhalten transparente Ergebnisse, eine fundierte Bewertung und auf Wunsch konkrete Handlungsempfehlungen zur Sanierung oder Prävention.
Schaffen Sie Sicherheit für Gesundheit, Bausubstanz und Werterhalt – wir beraten Sie gerne individuell.